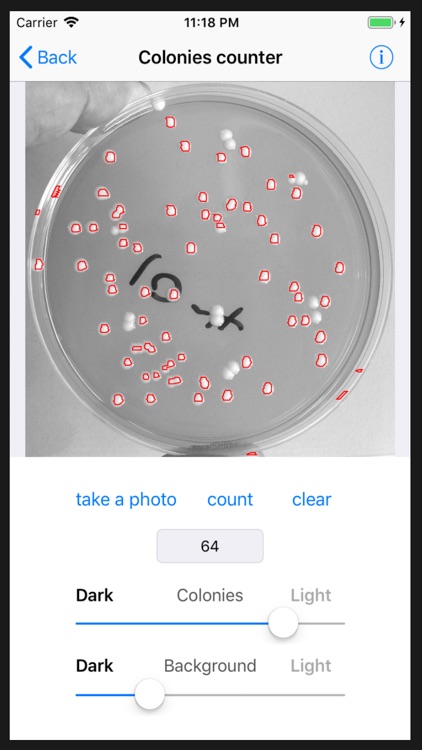
BioLabCalculators

You are using an outdated browser. Please
upgrade your browser to improve your experience.
It also includes a colonies counter
BioLabCalculators
by Valeriy Tarasov



What is it about?
It also includes a colonies counter. The photo of a Petri dish can be directly taken by iPhone camera or imported from the iPhone photo library.

App Screenshots

App Store Description
It also includes a colonies counter. The photo of a Petri dish can be directly taken by iPhone camera or imported from the iPhone photo library.
The provided calculators and converters:
Dilution calculator,
Molarity calculator,
Ligation calculator,
SDS PAG calculator,
Ammonium sulfate calculator,
Bacteria growth calculator,
Nucleic acid OD calculator,
Nucleic acid amount converter,
Protein amount converter
Disclaimer:
AppAdvice does not own this application and only provides images and links contained in the iTunes Search API, to help our users find the best apps to download. If you are the developer of this app and would like your information removed, please send a request to takedown@appadvice.com and your information will be removed.
AppAdvice does not own this application and only provides images and links contained in the iTunes Search API, to help our users find the best apps to download. If you are the developer of this app and would like your information removed, please send a request to takedown@appadvice.com and your information will be removed.